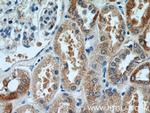
DDX10 Antibody in Immunohistochemistry (Paraffin) (IHC (P))

Search
Proteintech
DDX10 Polyclonal Antibody
{{$productOrderCtrl.translations['antibody.pdp.commerceCard.promotion.promotions']}}
{{$productOrderCtrl.translations['antibody.pdp.commerceCard.promotion.viewpromo']}}
{{$productOrderCtrl.translations['antibody.pdp.commerceCard.promotion.promocode']}}: {{promo.promoCode}} {{promo.promoTitle}} {{promo.promoDescription}}. {{$productOrderCtrl.translations['antibody.pdp.commerceCard.promotion.learnmore']}}
产品信息
17857-1-AP
种属反应
已发表种属
宿主/亚型
分类
类型
抗原
偶联物
形式
浓度
规格
纯化类型
保存液
内含物
保存条件
运输条件
产品详细信息
Immunogen sequence: IGLALQGKD VLGAAKTGSG KTLAFLVPVL EALYRLQWTS TDGLGVLIIS PTRELAYQTF EVLRKVGKNH DFSAGLIIGG KDLKHEAERI NNINILVCTP GRLLQHMDET VSFHATDLQM LVLDEADRIL DMGFADTMNA VIENLPKKRQ TLLFSATQTK SVKDLARLSL KNPEYVWVHE KAKYSTPATL EQNYIVCELQ QKISVLYSFL RSHLKKKSIV FFSSCKEVQY LYRVFCRLRP GVSILALHGR QQQMRRMEVY NEFVRKRAAV LFATDIAARG LDFPAVNWVL QFDCPEDANT YIHRAGRTAR YKEDGEALLI LLPSEKAMVQ QLL (100-431 aa encoded by BC091521)
靶标信息
DEAD box proteins, characterized by the conserved motif Asp-Glu-Ala-Asp (DEAD), are putative RNA helicases. They are implicated in a number of cellular processes involving alteration of RNA secondary structure such as translation initiation, nuclear and mitochondrial splicing, and ribosome and spliceosome assembly. Based on their distribution patterns, some members of this family are believed to be involved in embryogenesis, spermatogenesis, and cellular growth and division. This gene encodes a DEAD box protein, and it may be involved in ribosome assembly. Fusion of this gene and the nucleoporin gene, NUP98, by inversion 11 (p15q22) chromosome translocation is found in the patients with de novo or therapy-related myeloid malignancies.
仅用于科研。不用于诊断过程。未经明确授权不得转售。
生物信息学
蛋白别名: DDX10-NUP98 fusion protein type 2; DEAD (Asp-Glu-Ala-Asp) box polypeptide 10; DEAD box protein 10; DEAD/H (Asp-Glu-Ala-Asp/His) box polypeptide 10 (RNA helicase); Probable ATP-dependent RNA helicase DDX10; similar to DEAD box RNA helicases; unnamed protein product
基因别名: 4632415A01Rik; AI646054; Dbp4; DDX10; HRH-J8
UniProt ID: (Human) Q13206, (Mouse) Q80Y44
Entrez Gene ID: (Human) 1662, (Rat) 300710, (Mouse) 77591